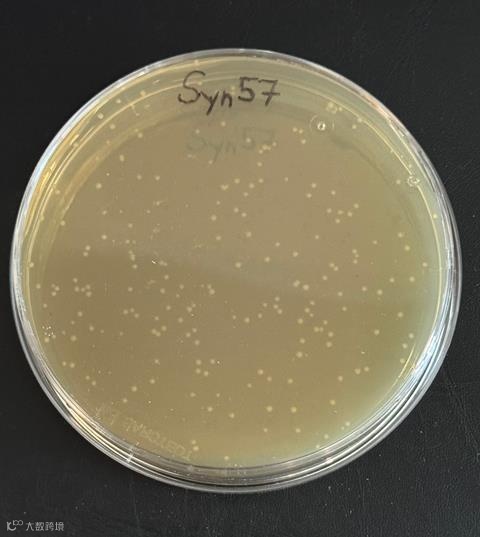

引言
在自然界,生命一般利用 64 种三联密码子编码20种氨基酸和3个终止密码子。
这意味着密码子具有简并性,即通常一种氨基酸对应1-6种不同数量的密码子编码。
来自剑桥大学的科研工作者一直在探索密码子压缩的边界,这一次他们证明,57种密码子编码20种氨基酸与终止信号时,遗传编码依然能正常运行。而Syn57菌株,不仅是目前遗传密码压缩程度最高的菌株,更为合成生物学、病毒抗性、新型化合物生成等开辟了全新平台。


压缩生命密码的极限实验

生命体通用的遗传密码子表具有冗余性,科学家们一直在设想:是否可以删除一些重复的密码子,能腾出更多的空间用于新的氨基酸编码,赋予它们全新的意义。
英国 MRC 分子生物学实验室(LMB)的 Jason Chin 团队在 2019 年合成了 Syn61,删除了 3 个密码子,其中包括1 个终止密码子和2个丝氨酸密码子。而这一次,他们更大胆地去掉了 4 个丝氨酸密码子、2 个丙氨酸密码子和 1 个终止密码子,让密码子总数缩减到 57 个——这是生命迄今能承受的最大“删减率”。

十万次改写,三十八块拼图

为了让基因组接受这场大规模删减,研究团队必须在 4 Mb的大肠杆菌基因组中完成101,605 个目标密码子的精准替换。他们将基因组拆分成 38 块“拼图”,每块约 10 万碱基,在酵母中合成、验证,然后用改良的 uREXER 技术(融合 CRISPR-Cas9 与 λ-Red 重组系统)一步步替换进大肠杆菌的基因组中。

Syn57菌株构建过程中丝氨酸与丙氨酸的密码子以及一个终止密码子被删除,整个过程涉及超过101,000的改写。
大肠杆菌基因组重编码的过程中,27 个片段可一次性完全重编码而11 个片段存在 60 kb “顽固区” 无法直接替换。科研人员不得不优化起始编码序列、重新设计重叠基因,并微调替换方案,最终才让所有“拼图”契合到一起。通过多轮组装与结合转移,Syn57 终于诞生——它虽然生长速度不如普通菌株,但已经足够在实验室里稳定生长。
通过压缩大肠杆菌基因组,
7个密码子被压缩创造出syn57菌株,可以正常生长。
图源:英国 MRC 分子生物学实验室

释放密码子空间,创造新生命功能

压缩遗传密码子并不是为了“简洁好看”,而是为了释放密码子空间方便重新利用。多余出来的 7 个密码子,可以被重新定义,用来编码非天然氨基酸,进而生产自然界从未出现的蛋白质、药物分子和高分子材料,例如具备特殊化学性能的聚合物。
正如研究负责人 Wesley Robertson 所说:“以目前的技术,这可能是生命所能承受的最极限压缩代码。” 下一步,他们将专注探索 Syn57 在材料合成、生物安全和工业生产中的潜力,而不是盲目继续压缩密码子数量——毕竟,这场“重写生命的语言”的旅程,才刚刚开始。
原文参考:
Syn57 represents a new chapter in the genetic code of life
https://www2.mrc-lmb.cam.ac.uk/syn57-represents-a-new-chapter-in-the-genetic-code-of-life/



